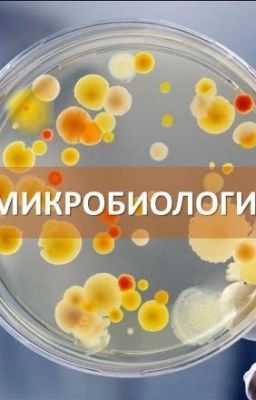
Микробиология (Вау)

Наука истории
2015духовные-практикимагический-реализмчакрыянг-адалтгеройвмаскетаинственныйгеройзубрилаобломпредсказаниеромфэнтезиследующиетерраарабыбогатыйнаследникбогаятыйнаследниквысшийсветdanyamilokhinjuliagavrilinamilokhinоткровеннаяэротика1любовныероманы

Приключения мышек
DashaO_1
39

Больше, чем просто друзья
ravungen137
15

Архивы Хэднела
benjaminfein
81

Наука
muslimlife_kz
26

Катализатор
alseniaaa
18
Микробиология (Вау)
FuraViking
108

Странствия Чёрной Тени
Alex_Sapientiae
152

Дезин-сектор
JustWudlike
123

Переплетение миров
RemideZager
2

Валентина Героинова
Misae-sama
7

Культивирование любви
KateKrupp
192

Студенты против малолеток. Или Как успешно организовать свою жизнь будучи рабом
QuinnpinD
2

Прямиком в бездну
sonya_bronshtein
106

Мой Паучок
Dokkaebi935
21К

Империя мёртвых/Shisha no Teikoku
UselessAlone
612

Техника безопасности
uliiva
7

Выживший
ValtteriZ
845

Воля случая/Струны моей души
AliceParker7
32

Небесные Музы
karrddeellen
77

mini. knowledge
young_juliet
425